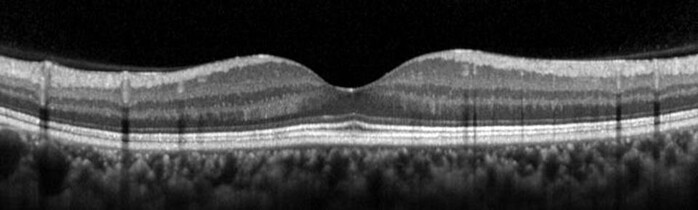

-인지기능에 영향 미치는 망막층 종류 무엇인지 연구마다 결과 다르고 한국인 대상 연구 없어
-성남시 거주 노인 430명 대상 망막 두께 측정 및 주기적인 인지기능 검사 실시
-망막 ‘신경섬유층’ 두께 하위 25%, 향후 치매 유병률 대조군 대비 약 5배 높아
-망막 구조와 인지기능 관련성 밝힌 한국 최초 연구
-장기추적 통해 망막 구조와 미래 인지기능 저하 간 관
![]() |
| ▲분당서울대병원 안과 우세준 교수(좌), 정신건강의학과 김기웅 교수(우) |
분당서울대병원 안과 우세준 교수, 김기웅 교수 연구팀이 망막 황반부의 신경섬유층 두께가 얇을수록 향후 인지기능장애를 겪을 위험이 높다는 사실을 대규모 코호트 연구를 통해 밝혀냈다.
망막은 우리 눈의 가장 안쪽에 있는 신경 세포의 막으로, 빛을 감지하고 시각정보를 처리, 통합해 대뇌로 전달하는 역할을 한다. 이러한 망막은 신체 노화가 진행될수록 두께가 얇아지면서 시신경의 기능 또한 함께 저하되는데, 최근 망막층 두께 감소와 인지기능 저하 사이의 연관성이 밝혀지며 치매를 평가할 수 있는 인자로써 학계의 주목받고 있다.
이에 따라 다양한 연구가 진행됐으나 대규모 표본으로 장기간 수행된 연구는 희박했고, 10개로 이뤄진 망막층 중 어떤 것이 인지기능에 직접적인 영향을 미치는지에 대해서는 연구마다 결과에 차이가 있었다. 특히 국내에서는 관련한 연구 자체가 없어 한국인 망막 구조와 인지기능 저하 간의 연관성을 입증할 구체적인 근거가 매우 부족한 상황이었다.
이러한 가운데 우세준, 김기웅 교수 연구팀은 성남시 거주 노인인구 430명을 대상으로 초기 망막 두께를 측정하고, 망막 두께에 따라 이후 5년 동안 정기적으로 시행한 인지기능 검사 결과에 어떤 차이가 있었는지를 분석하는 연구를 수행했다. 망막 두께의 정밀 분석에는 ‘빛간섭단층촬영’ 방법이 사용됐다.
![]() |
| ▲망막 두께를 정밀 분석하는 ‘빛간섭단층촬영’ 영상 |
그 결과, 여러 망막층 중 황반부의 신경섬유층(Retinal Nerve Fiber Layer)의 두께가 하위 25%(231마이크로미터 이하)에 해당하는 경우 치매 발생확률이 약 5배 이상 높은 것으로 나타났다. 이밖에 속얼기층(Inner Plexiform Layer) 등 다른 망막층은 미래 인지기능 저하와 뚜렷한 연관성을 보이지 않았다.
연구 결과에 따르면 신경섬유층이 얇은 노인은 인지기능 평가 점수(CERAD-TS)가 초기 평균 65.4점에서 시작하여 매년 3.79점 감소해 신경섬유층이 두꺼운 노인층(68.5점 시작, 연 2.42점 감소)보다 인지기능이 떨어지고 향후 인지기능의 감소 폭 역시 가파른 것으로 나타났다. 이러한 양상은 또 다른 인지기능 평가 도구인 MMSE 검사에서도 동일했다.
| ▲망막 신경섬유층 두께가 얇은 노인(주황색)의 인지기능 점수가 두꺼운 노인(파란색)보다 낮고, 감소폭도 더욱 가파르다 |
이로 인해 황반부 신경섬유층 두께가 얇은 그룹에서 향후 경도인지장애 혹은 알츠하이머병을 가지게 될 확률은 52.7%로, 대조군의 유병 비율 11.3%를 크게 웃돌며 인지기능장애의 위험도가 약 5배 이상 높았다.
이와 같은 결과는 한국 최초로 노인 인구에서 인지기능과 망막 구조의 관련성을 밝힌 연구이자, 장기적인 추적 관찰을 통해 망막 구조와 미래 인지기능 저하 간의 관계를 규명한 세계 최초의 연구로서 의미가 깊다.
안과 우세준 교수는 “이번 연구를 통해 황반부 신경섬유층의 두께를 측정하고 이를 바탕으로 인지기능장애의 위험도를 예측할 수 있다는 사실을 입증했다”며, “임상 현장에서 인지기능장애의 조기 진단 및 치료에 활용할 수 있는 가능성도 높다”고 밝혔다.
이어 정신건강의학과 김기웅 교수는 “알츠하이머병 등의 인지기능장애와 연관된 다양한 요인들이 규명되고 있다”며, “망막 구조가 인지기능에 영향을 미치는 기전을 밝혀낸다면 치료법 발전에도 큰 도움이 될 것”이라고 말했다.
한편, 이번 연구 결과는 세계적 학술지 ‘미국의학협회 안과학 저널(JAMA Ophthalmology)’에 최근 게재됐다.[로컬세계 = 마나미 기자]
[저작권자ⓒ 로컬(LOCAL)세계. 무단전재-재배포 금지]